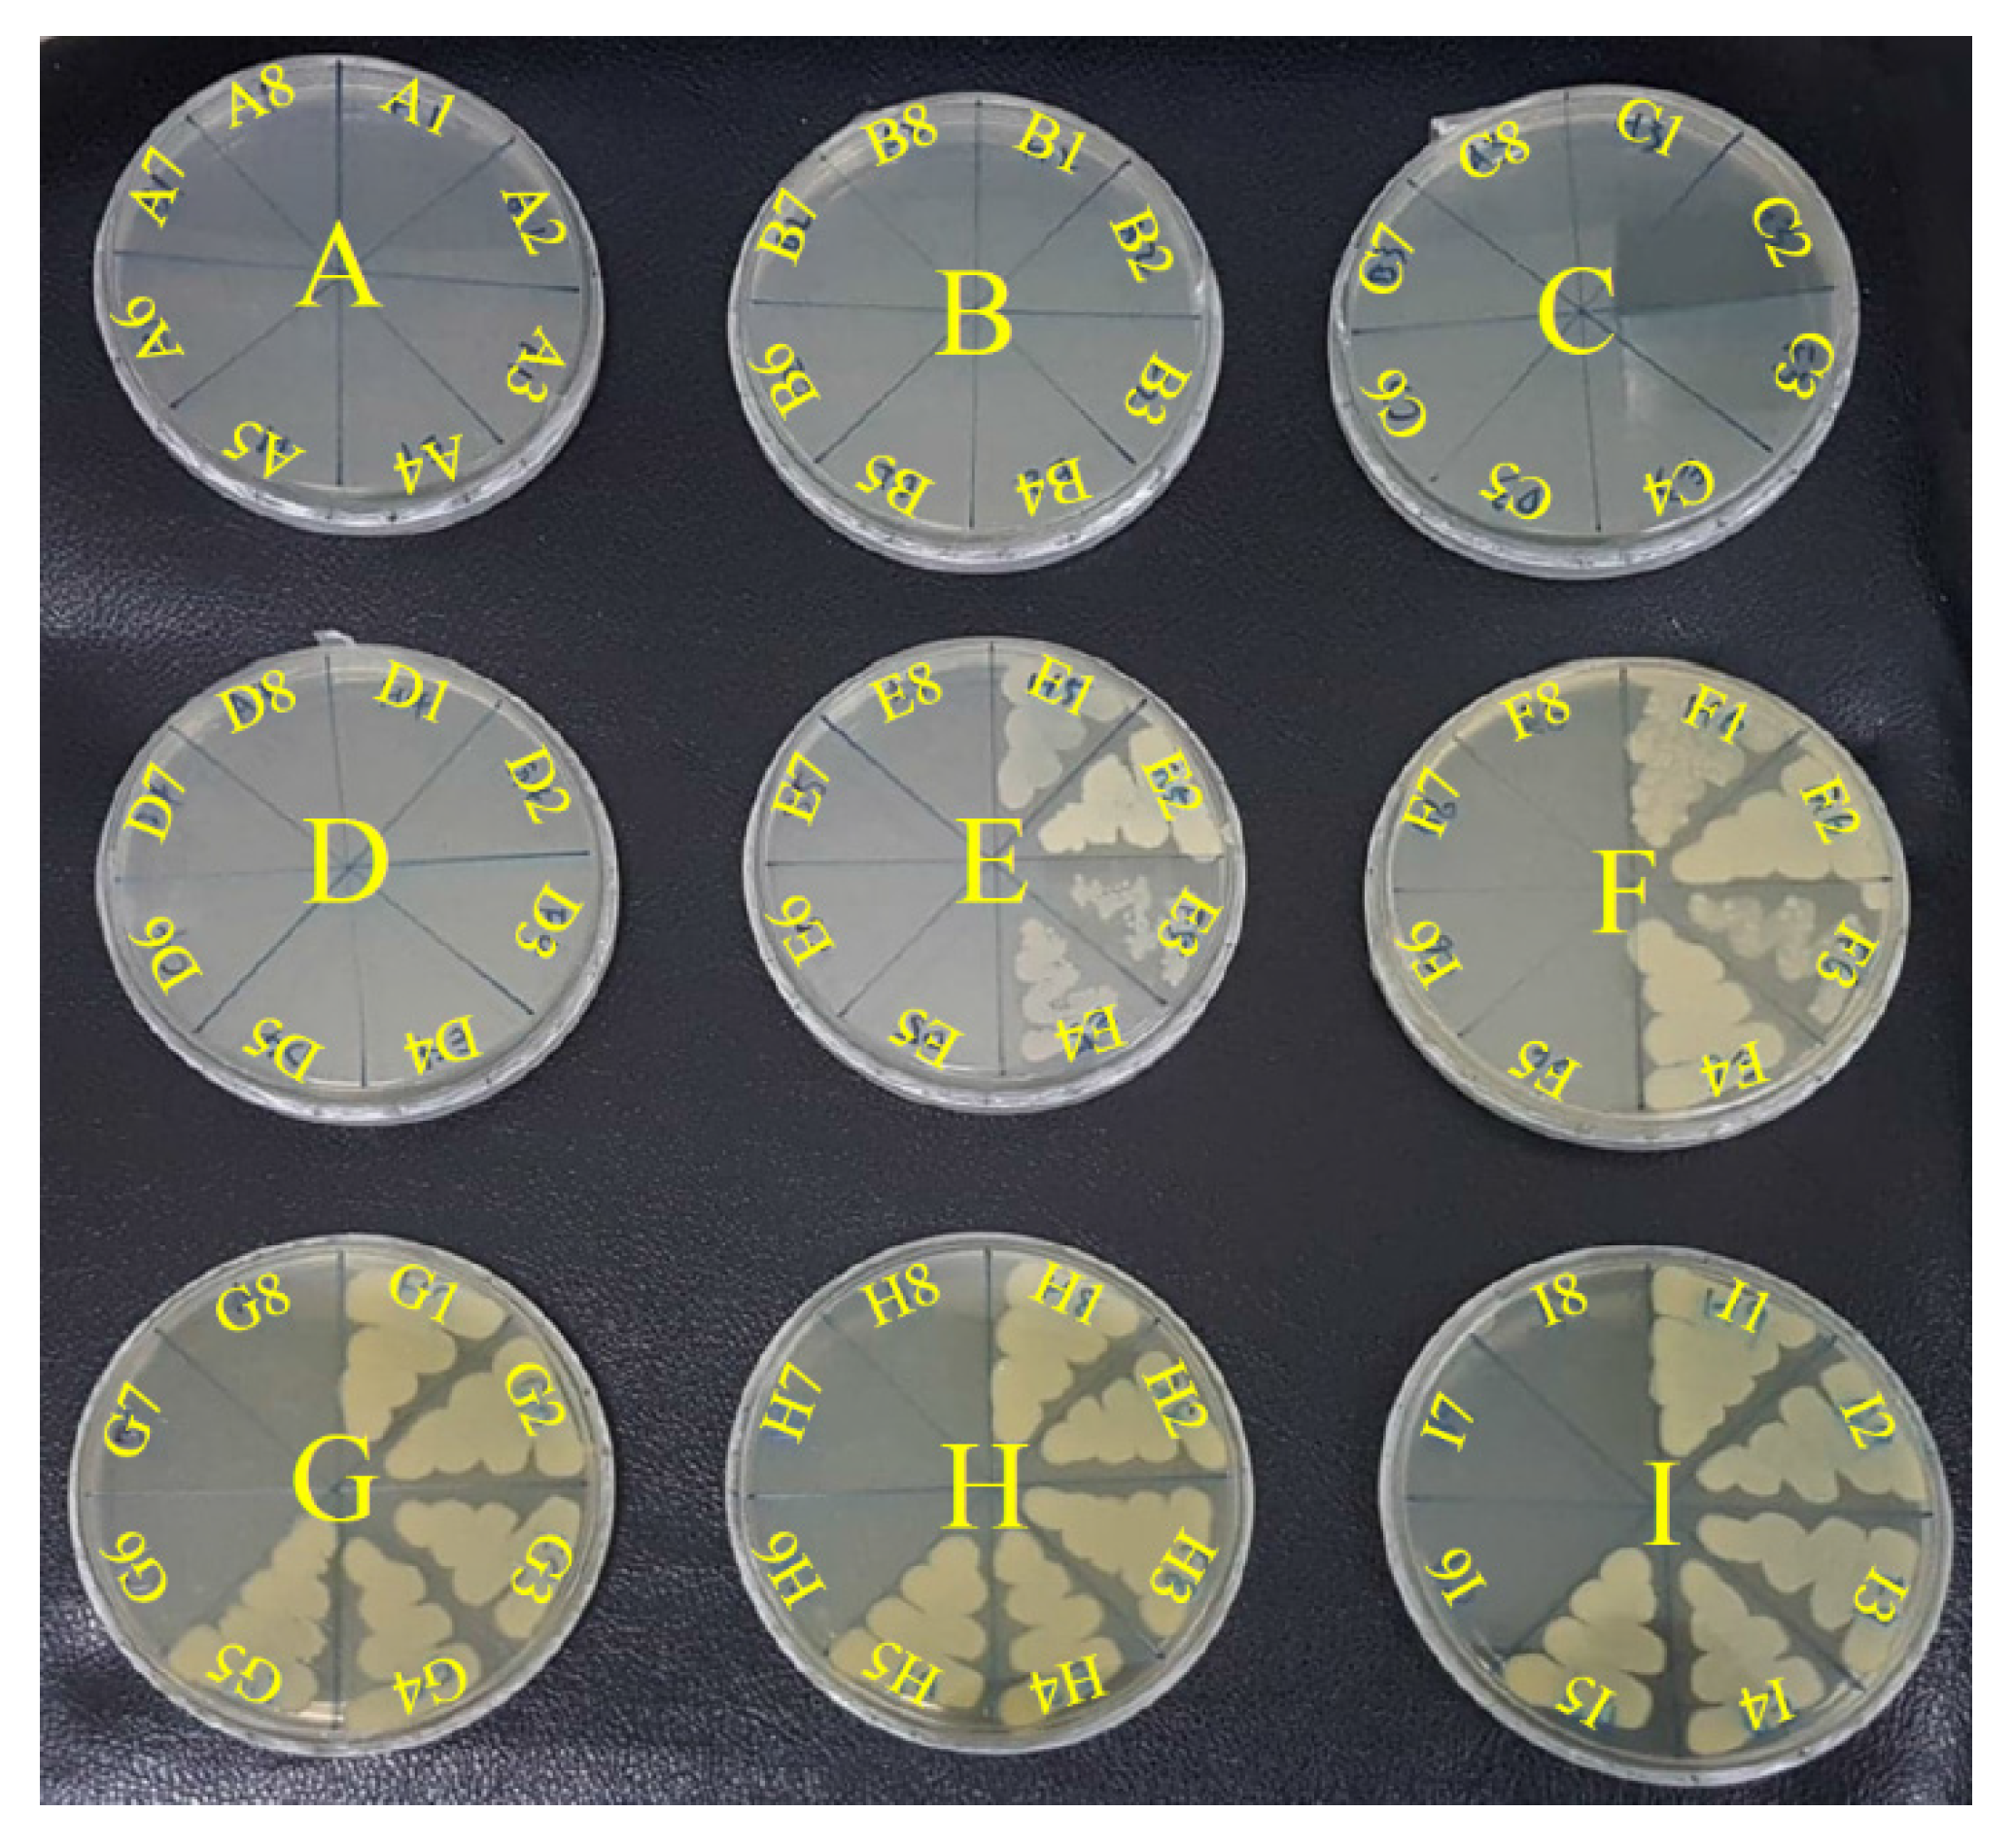
Polymers 13 01529 g005 Polymers 13 01529 g005

Synergistic Antibacterial Effect of Casein-AgNPs Combined with Tigecycline against Acinetobacter baumannii
Abstract
1. Introduction
2. Materials and Methods
2.1. Materials
2.2. Synthesis of the SSCP
2.3. Synthesis of Casein/Arginine-AgNPs Reagent
2.4. Characterization of Casein/Arginine-AgNPs
2.5. In Vitro Antibacterial Test
2.5.1. Bacteria Culture and Conservation
2.5.2. Time-Kill Kinetic Assay
Determination of Minimal Inhibitory Concentration (MIC)
Determination of Minimal Bactericidal Concentration (MBC)
Checkerboard Assay
2.6. Statistical Analysis of Data
3. Results and Discussion
3.1. Nanomaterial Characteristics
3.2. Antibacterial Activity of Casein/Arginine-AgNPs
3.3. Synergy Effect of the Combination of Tigecycline and Casein/Arginine-AgNPs
4. Conclusions
Author Contributions
Funding
Institutional Review Board Statement
Informed Consent Statement
Data Availability Statement
Acknowledgments
Conflicts of Interest
References
- Deng, H.; McShan, D.; Zhang, Y.; Sinha, S.S.; Arslan, Z.; Ray, P.C.; Yu, H. Mechanistic Study of the Synergistic Antibacterial Activity of Combined Silver Nanoparticles and Common Antibiotics. Environ. Sci. Technol. 2016, 50, 8840–8848. [Google Scholar] [CrossRef] [PubMed]
- Tseng, S.P.; Hung, W.C.; Huang, C.Y.; Lin, Y.S.; Chan, M.Y.; Lu, P.L.; Lin, L.; Sheu, J.H. 5-Episinuleptolide Decreases the Expression of the Extracellular Matrix in Early Biofilm Formation of Multi-Drug Resistant Acinetobacter baumannii. Mar. Drugs 2016, 14, 143. [Google Scholar] [CrossRef]
- Krausz, A.E.; Adler, B.L.; Cabral, V.; Navati, M.; Doerner, J.; Charafeddine, R.A.; Chandra, D.; Liang, H.; Gunther, L.; Clendaniel, A.; et al. Curcumin-encapsulated nanoparticles as innovative antimicrobial and wound healing agent. Nanomedicine 2015, 11, 195–206. [Google Scholar] [CrossRef] [PubMed]
- Towner, K.J. Acinetobacter: An old friend, but a new enemy. J. Hosp. Infect. 2009, 73, 355–363. [Google Scholar] [CrossRef]
- Mussi, M.A.; Limansky, A.S.; Viale, A.M. Acquisition of resistance to carbapenems in multidrug-resistant clinical strains of Acinetobacter baumannii: Natural insertional inactivation of a gene encoding a member of a novel family of beta-barrel outer membrane proteins. Antimicrob. Agents Chemother. 2005, 49, 1432–1440. [Google Scholar] [CrossRef]
- Leekha, S.; Terrell, C.L.; Edson, R.S. General principles of antimicrobial therapy. Mayo Clin. Proc. 2011, 86, 156–167. [Google Scholar] [CrossRef]
- Garnacho-Montero, J.; Timsit, J.F. Managing Acinetobacter baumannii infections. Curr. Opin. Infect. Dis. 2018, 32, 69–76. [Google Scholar] [CrossRef] [PubMed]
- Shen, F.; Han, Q.; Xie, D.; Fang, M.; Zeng, H.; Deng, Y. Efficacy and safety of tigecycline for the treatment of severe infectious diseases: An updated meta-analysis of RCTs. Int. J. Infect. Dis. 2015, 39, 25–33. [Google Scholar] [CrossRef]
- Tasina, E.; Haidich, A.-B.; Kokkali, S.; Arvanitidou, M. Efficacy and safety of tigecycline for the treatment of infectious diseases: A meta-analysis. Lancet Infect. Dis. 2011, 11, 834–844. [Google Scholar] [CrossRef]
- Cai, Y.; Wang, R.; Liang, B.; Bai, N.; Liu, Y. Systematic review and meta-analysis of the effectiveness and safety of tigecycline for treatment of infectious disease. Antimicrob. Agents Chemother. 2011, 55, 1162–1172. [Google Scholar] [CrossRef]
- Mourino, V.; Cattalini, J.P.; Boccaccini, A.R. Metallic ions as therapeutic agents in tissue engineering scaffolds: An overview of their biological applications and strategies for new developments. J. R. Soc. Interface 2012, 9, 401–419. [Google Scholar] [CrossRef] [PubMed]
- Hoppe, A.; Mourino, V.; Boccaccini, A.R. Therapeutic inorganic ions in bioactive glasses to enhance bone formation and beyond. Biomater. Sci. 2013, 1, 254–256. [Google Scholar] [CrossRef]
- Chernousova, S.; Epple, M. Silver as antibacterial agent: Ion, nanoparticle, and metal. Angew. Chem. Int. Ed. 2013, 52, 1636–1653. [Google Scholar] [CrossRef]
- Hebbalalu, D.; Lalley, J.; Nadagouda, M.N.; Varma, R.S. Greener Techniques for the Synthesis of Silver Nanoparticles Using Plant Extracts, Enzymes, Bacteria, Biodegradable Polymers, and Microwaves. ACS Sustain. Chem. Eng. 2013, 1, 703–712. [Google Scholar] [CrossRef]
- Ashraf, S.; Abbasi, A.Z.; Pfeiffer, C.; Hussain, S.Z.; Khalid, Z.M.; Gil, P.R.; Parak, W.J.; Hussain, I. Protein-mediated synthesis, pH-induced reversible agglomeration, toxicity and cellular interaction of silver nanoparticles. Colloids Surf. B Biointerfaces 2013, 102, 511–518. [Google Scholar] [CrossRef]
- Ullah, N.; Li, D.; Xiaodong, C.; Yasin, S.; Umair, M.M.; Van Eede, S.S.; Wei, Q. Photo-Irradiation Based Biosynthesis of Silver Nanoparticles by Using an Ever Green Shrub and Its Antibacterial Study. Dig. J. Nanomater. Biostruct. 2015, 10, 95–106. [Google Scholar]
- Saratale, R.G.; Saratale, G.D.; Ghodake, G.; Cho, S.K.; Kadam, A.; Kumar, G.; Jeon, B.H.; Pant, D.; Bhatnagar, A.; Shin, H.S. Wheat straw extracted lignin in silver nanoparticles synthesis: Expanding its prophecy towards antineoplastic potency and hydrogen peroxide sensing ability. Int. J. Biol. Macromol. 2019, 128, 391–400. [Google Scholar] [CrossRef]
- Memon, H.; Wang, H.; Yasin, S.; Halepoto, A. Influence of Incorporating Silver Nanoparticles in Protease Treatment on Fiber Friction, Antistatic, and Antibacterial Properties of Wool Fibers. J. Chem. 2018, 2018, 4845687. [Google Scholar] [CrossRef]
- Saratale, G.D.; Saratale, R.G.; Kim, D.S.; Kim, D.; Shin, H.S. Exploiting Fruit Waste Grape Pomace for Silver Nanoparticles Synthesis, Assessing Their Antioxidant, Antidiabetic Potential and Antibacterial Activity against Human Pathogens: A Novel Approach. Nanomaterials 2020, 10, 1457. [Google Scholar] [CrossRef]
- Saratale, R.G.; Shin, H.S.; Kumar, G.; Benelli, G.; Ghodake, G.S.; Jiang, Y.Y.; Kim, D.S.; Saratale, G.D. Exploiting fruit byproducts for eco-friendly nanosynthesis: Citrus x clementina peel extract mediated fabrication of silver nanoparticles with high efficacy against microbial pathogens and rat glial tumor C6 cells. Environ. Sci. Pollut. Res. 2018, 25, 10250–10263. [Google Scholar] [CrossRef]
- Ullah, N.; Yasin, S.; Abro, Z.; Liu, L.; Wei, Q.F. Mechanically Robust and Antimicrobial Cotton Fibers Loaded with Silver Nanoparticles: Synthesized via Chinese Holly Plant Leaves. Int. J. Text. Sci. 2014, 3, 1–5. [Google Scholar] [CrossRef]
- Jiang, B.; Wang, X.J.; Wang, L.L.; Wu, S.; Li, D.M.; Liu, C.H.; Feng, Z.B. Fabrication and Characterization of a Microemulsion Stabilized by Integrated Phosvitin and Gallic Acid. J. Agric. Food Chem. 2020, 68, 5437–5447. [Google Scholar] [CrossRef] [PubMed]
- Wang, Q.N.; Liu, W.H.; Tian, B.; Li, D.M.; Liu, C.H.; Jiang, B.; Feng, Z.B. Preparation and Characterization of Coating Based on Protein Nanofibers and Polyphenol and Application for Salted Duck Egg Yolks. Foods 2020, 9, 449. [Google Scholar] [CrossRef]
- Zhang, Y.; Liang, S.; Zhang, J.S.; Chi, Y.J.; Tian, B.; Li, L.L.; Jiang, B.; Li, D.M.; Feng, Z.B.; Liu, C.H. Preparation of whey protein isolate nanofibrils by microwave heating and its application as carriers of lipophilic bioactive substances. LWT-Food Sci. Technol. 2020, 125, 109213. [Google Scholar] [CrossRef]
- Li, P.; Li, J.; Wu, C.; Wu, Q.; Li, J. Synergistic antibacterial effects of β-lactam antibiotic combined with silver nanoparticles. Nanotechnology 2005, 16, 1912–1917. [Google Scholar] [CrossRef]
- Fayaz, A.M.; Balaji, K.; Girilal, M.; Yadav, R.; Kalaichelvan, P.T.; Venketesan, R. Biogenic synthesis of silver nanoparticles and their synergistic effect with antibiotics: A study against gram-positive and gram-negative bacteria. Nanomedicine 2010, 6, 103–109. [Google Scholar] [CrossRef]
- Pajares-Chamorro, N.; Shook, J.; Hammer, N.D.; Chatzistavrou, X. Resurrection of antibiotics that methicillin-resistant Staphylococcus aureus resists by silver-doped bioactive glass-ceramic microparticles. Acta Biomater. 2019, 96, 537–546. [Google Scholar] [CrossRef]
- Yahav, D.; Lador, A.; Paul, M.; Leibovici, L. Efficacy and safety of tigecycline: A systematic review and meta-analysis. J. Antimicrob. Chemother. 2011, 66, 1963–1971. [Google Scholar] [CrossRef]
- Chien, C.-S.; Lin, C.-J.; Ko, C.-J.; Tseng, S.-P.; Shih, C.-J. Antibacterial activity of silver nanoparticles (AgNP) confined to mesostructured silica against methicillin-resistant Staphylococcus aureus (MRSA). J. Alloys Compd. 2018, 747, 1–7. [Google Scholar] [CrossRef]
- Chou, T.C. Drug combination studies and their synergy quantification using the Chou-Talalay method. Cancer Res. 2010, 70, 440–446. [Google Scholar] [CrossRef]
- Wang, Y.; Ding, X.L.; Chen, Y.; Guo, M.Q.; Zhang, Y.; Guo, X.K.; Gu, H.C. Antibiotic-loaded, silver core-embedded mesoporous silica nanovehicles as a synergistic antibacterial agent for the treatment of drug-resistant infections. Biomaterials 2016, 101, 207–216. [Google Scholar] [CrossRef]
- Kung, J.-C.; Chen, Y.-J.; Chiang, Y.-C.; Lee, C.-L.; Yang-Wang, Y.-T.; Hung, C.-C.; Shih, C.-J. Antibacterial activity of silver nanoparticle (AgNP) confined mesoporous structured bioactive powder against Enterococcus faecalis infecting root canal systems. J. Non-Cryst. Solids 2018, 502, 62–70. [Google Scholar] [CrossRef]
- Agnihotri, S.; Bajaj, G.; Mukherji, S.; Mukherji, S. Arginine-assisted immobilization of silver nanoparticles on ZnO nanorods: An enhanced and reusable antibacterial substrate without human cell cytotoxicity. Nanoscale 2015, 7, 7415–7429. [Google Scholar] [CrossRef]
- Shoeib, T.; Siu, K.W.M.; Hopkinson, A.C. Silver ion binding energies of amino acids: Use of theory to assess the validity of experimental silver ion basicities obtained from the kinetic method. J. Phys. Chem. A 2002, 106, 6121–6128. [Google Scholar] [CrossRef]
- Yang, T.-Y.; Hsieh, Y.-J.; Lu, P.-L.; Lin, L.; Wang, L.-C.; Wang, H.-Y.; Tsai, T.-H.; Shih, C.-J.; Tseng, S.-P. In vitro and in vivo assessments of inspired ag/80S bioactive nanocomposites against carbapenem-resistant Klebsiella pneumoniae. Mater. Sci. Eng. C 2021, 125, 112093. [Google Scholar] [CrossRef]
- Li, S.K.; Shen, Y.H.; Xie, A.J.; Yu, X.R.; Qiu, L.G.; Zhang, L.; Zhang, Q.F. Green synthesis of silver nanoparticles using Capsicum annuum L. extract. Green Chem. 2007, 9, 852–858. [Google Scholar] [CrossRef]
- Kusano, K.; Waterman, M.R.; Sakaguchi, M.; Omura, T.; Kagawa, N. Protein Synthesis Inhibitors and Ethanol Selectively Enhance Heterologous Expression of P450s and Related Proteins in Escherichia coli. Arch. Biochem. Biophys. 1999, 367, 129–136. [Google Scholar] [CrossRef]
- Lok, C.-N.; Ho, C.-M.; Chen, R.; He, Q.-Y.; Yu, W.-Y.; Sun, H.; Tam, P.K.-H.; Chiu, J.-F.; Che, C.-M. Silver nanoparticles: Partial oxidation and antibacterial activities. JBIC J. Biol. Inorg. Chem. 2007, 12, 527–534. [Google Scholar] [CrossRef]
- Akram, F.E.; El-Tayeb, T.; Abou-Aisha, K.; El-Azizi, M. A combination of silver nanoparticles and visible blue light enhances the antibacterial efficacy of ineffective antibiotics against methicillin-resistant Staphylococcus aureus (MRSA). Ann. Clin. Microbiol. Antimicrob. 2016, 15, 48. [Google Scholar] [CrossRef]

| Silver Reagent | Size Distribution of AgNPs (nm) | Average Size of AgNPs (nm) |
|---|---|---|
| Casein-AgNPs | 1.7–4.6 | 2.9 ± 0.8 |
| Casein/arginine-AgNPs | 10.3–24.2 | 17.0 ± 4.5 |
| Casein/arginine-AgNPs (after 3 months) | 8.6–30.8 | 17.2 ± 4.2 |
| Sample Name | MIC of Tigecycline (µg/mL) | MIC of Casein/Arginine-AgNPs (mg/mL) | CI |
|---|---|---|---|
| Casein/arginine-AgNPs and Tigecycline | 0.16 | 1.25 | 0.88 |
| 0.31 | 0.63 | 0.88 | |
| 0.31 | 0.31 | 0.69 | |
| 0.31 | 0.16 | 0.59 |
Publisher’s Note: MDPI stays neutral with regard to jurisdictional claims in published maps and institutional affiliations. |
© 2021 by the authors. Licensee MDPI, Basel, Switzerland. This article is an open access article distributed under the terms and conditions of the Creative Commons Attribution (CC BY) license (https://creativecommons.org/licenses/by/4.0/).
Share and Cite
Chen, Y.-H.; Wang, W.-H.; Lin, S.-H.; Yang-Wang, Y.-T.; Tseng, S.-P.; Chien, C.-S.; Shih, C.-J. Synergistic Antibacterial Effect of Casein-AgNPs Combined with Tigecycline against Acinetobacter baumannii. Polymers 2021, 13, 1529. https://doi.org/10.3390/polym13091529
Chen Y-H, Wang W-H, Lin S-H, Yang-Wang Y-T, Tseng S-P, Chien C-S, Shih C-J. Synergistic Antibacterial Effect of Casein-AgNPs Combined with Tigecycline against Acinetobacter baumannii. Polymers. 2021; 13(9):1529. https://doi.org/10.3390/polym13091529
Chicago/Turabian StyleChen, Yu-Hsuan, Wei-Hsun Wang, Sheng-Hui Lin, Yuan-Ting Yang-Wang, Sung-Pin Tseng, Chi-Sheng Chien, and Chi-Jen Shih. 2021. "Synergistic Antibacterial Effect of Casein-AgNPs Combined with Tigecycline against Acinetobacter baumannii" Polymers 13, no. 9: 1529. https://doi.org/10.3390/polym13091529
APA StyleChen, Y.-H., Wang, W.-H., Lin, S.-H., Yang-Wang, Y.-T., Tseng, S.-P., Chien, C.-S., & Shih, C.-J. (2021). Synergistic Antibacterial Effect of Casein-AgNPs Combined with Tigecycline against Acinetobacter baumannii. Polymers, 13(9), 1529. https://doi.org/10.3390/polym13091529
